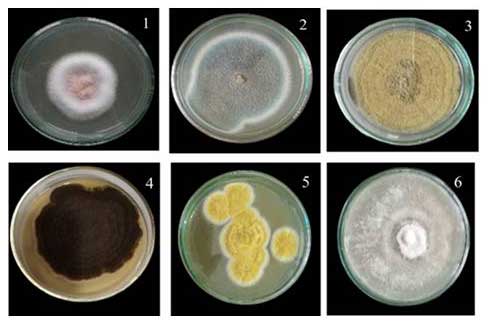

Songklanakarin Journal of Science and Technology (SJST)
Volume 47 No.5 (September - October 2025)
pp. 314 - 387
Orthogonal generalized reverse derivations in semiprime Γ-semirings
V.S.V. Krishna Murty, C. Jaya Subba Reddy and Sk. Haseena
Influence of quadrupole-needle direct corona discharge on degradation of methylene blue in water
Wasin Nupangtha, Kamtorn Saidarasamoot and Suebsak Suksaengpanomrung

Unveiling the impact of isolated phosphate-solubilizing fungi on soil fertility and sustainable agriculture: insights from physicochemical analysis and plant growth trials
Jayathilake K.M.P.I., Manage P.M and Idroos F. S
Cost-benefit analysis of municipal solid waste management in Myanmar
Thanwadee Chinda, Mo Mo and Seksan Papong

A new approach to improve the efficiency of intumescent flame retardant for polypropylene fibers
Pantisa Ruenpakdan, Toemsak Srikhirin, Karine Mougin, Marie-France Valla, Sophie Duquesne and Taweechai Amornsakchai

A systematic review on the effect of adding an intervention for balance in pulmonary rehabilitation program of chronic obstructive pulmonary disease patients.
Nahid Khan, Suresh Mani, Iqbal Alam and Abhinav Jain

Carbon neutrality implementation in Thailand: the use of analytic hierarchy process
Thanwadee Chinda, Chotika Trianongphat, Missinee Thuengwong, Naphat Thongnont, Ploybudhsara Jitsanguan and Rinrada Boonwat

Assessment of ankle functional performance in children with chronic ankle instability using functional performance tests and walking speed tests
Amornpan Ajjimaporn, Supannikar Yingyongsaksri, Kitiyawadee Srisim and Janya Chuadthong








